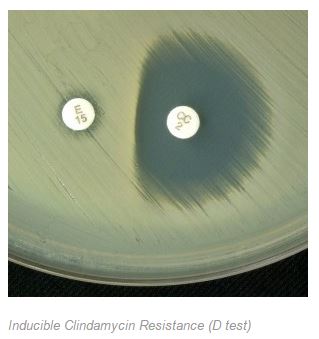

| Indicator antibiotic tested | Result | Extrapolates to | Also susceptible (but not first line) |
| Betalactamase production and/or penicillin susceptibility
|
Susceptible
i.e betalactamase negative
|
benzylpenicillin
ampicillin/ amox dicloxacillin flucloxacillin cephalexin cefazolin |
Later generation cephalosporins
Carbapenems Betalactam+betalactamase inhibitors including amoxycillin+clavulanate |
| Cefoxitin | Susceptible = the strain is NOT MRSA | di/flucloxacillin
cephalexin cefazolin |
|
| Cefoxitin | Resistant =
MRSA detected Confirmation – presence of mecA (or mecC) gene |
No betalactams other than ceftaroline can be used for treatment | Ceftaroline |
| Erythromycin | Susceptible | Azithromycin
Clarithromycin Clindamycin |
|
| Erythromycin
|
Resistant
Positive ‘D test’ to look for inducible clindamycin resistance |
Clindamycin is susceptible if the D test is negative (ie shows no evidence of inducible resistance (see below) | Note: as only a minority (10-20% ) of erythromycin resistant strains are clindamycin susceptible (D test negative), most labs do not do the D test and report Clinda as resistant based on the Erythromycin test result. This is a reliable strategy. |
| Tetracycline | Susceptible | Doxycycline | Tigecycline |
| Vancomycin
(broth micro-dilution method required) |
Susceptible
|
Teicoplanin
|
Note: most labs will also conduct an MIC test by the E-test method for isolates of MRSA from blood. Raised MICs 1.5mg/L or higher within the susceptible range are associated with worse patient outcomes. Testing for vancomycin-intermediate strains may also be indicated in some circumstances. |
Image from microbeonline.com.
Reblogged this on Infectious Diseases and Microbiology postgraduate teaching.
LikeLike
[…] MRSA is done by a cefoxitin 30 microgram disc test by the correct EUCAST or CLSI methodology. This posting discusses susceptibility of S. […]
LikeLike
[…] 80% of local methicillin-susceptible S. aureus is penicillin resistant by this mechanism. This post explains how to extrapolate penicillin and other antibiotic susceptibilities to related […]
LikeLike
[…] MRSA is done by a cefoxitin 30 microgram disc test by the correct EUCAST or CLSI methodology. This posting discusses susceptibility of S. […]
LikeLike
[…] MRSA is done by a cefoxitin 30 microgram disc test by the correct EUCAST or CLSI methodology. This posting discusses susceptibility of S. […]
LikeLike